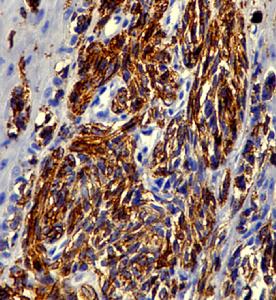
原發性食管惡性黑色素瘤

疾病概述
 原發性食管惡性黑色素瘤
原發性食管惡性黑色素瘤症狀體徵
 原發性食管惡性黑色素瘤
原發性食管惡性黑色素瘤疾病病因
 原發性食管惡性黑色素瘤
原發性食管惡性黑色素瘤Allen和Spitz在1953年就提出診斷起源於食管的惡性黑色素瘤的主要標準是靠近腫瘤的食管黏膜處有交界性改變(junctionalchanges)、典型的黑色素瘤的組織學表現並在瘤細胞內發現黑色素。Pava等(1963)報導對100例正常食管進行屍檢的過程中發現其中4例食管黏膜上皮的基底膜中有典型的成黑色素細胞、黑色素顆粒以及神經元樹突(2例成黑色素細胞位於食管上段,另外2例成黑色素細胞位於食管中段),食管黏膜中的成黑色素細胞來源於神經嵴(胚胎期神經管背側的細胞帶),即神經嵴形成的表皮黑色素細胞遊走到食管上皮的結果。此後,Tatteshi等(1974)和Ohashi等(1990)先後報導日本人正常食管黏膜中存在嗜銀細胞和黑色素細胞,發生率為8%,而且可以導致食管的黑色素沉著病(melanosis)。1970年,Piccon等報導了第1例食管原發性惡性黑色素瘤合併全食管黑色素沉著病。但是絕大多數食管黑色素瘤病人並無食管黑色素沉著病,這種腫瘤可能起源於其他更為常見的途徑:①起源於食管黏膜的正常成黑色素細胞;②起源於食管正常上皮細胞的化生;③或起源於胚胎髮育期間出現在食管上皮內的異位成黑色素細胞。現在一般認為食管黏膜的成黑色素細胞直接來自人胚胎時期的神經嵴,而食管原發性惡性黑色素瘤起源於食管基底膜(層)的成黑色素細胞。
病理生理
 原發性食管惡性黑色素瘤
原發性食管惡性黑色素瘤個別病例的腫瘤大體標本上無黑色素,然而在進行組織學檢查時瘤細胞內可見黑色素。典型的有色素沉著的食管黑色素瘤病人,毗鄰腫瘤的食管黏膜表現為黑變病或黑色素沉著病,這種改變可為局灶性,亦可為瀰漫性。DiConstanzo和Umacher(1987)報導,25%的食管黑色素瘤病人中可以看到這種表現。按黑色素瘤的診斷標準和更為嚴格的定義,組織學檢查發現瘤細胞內無黑色素的腫瘤在分類時應將其列為無黑色素性黑色素瘤(amelanoticmelanoma)。但大多數病例報導中並不堅持上述診斷標準與定義。採用這一標準者,真性無黑色素性黑色素瘤的發病率不到2%。
2.鏡下表現食管原發性惡性黑色素瘤的鏡下組織學特點與人體其他部位的惡性黑色素瘤的鏡下所見相同。腫瘤表面的食管鱗狀上皮多屬正常;瘤組織的結構呈多樣性,瘤細胞可排列成巢狀、條索狀或呈腺樣排列;瘤細胞的大小與形狀多比較一致,細胞較大,呈多邊形或梭形;細胞核也較大,常有粗大的嗜酸性核仁,核分裂象多見;胞漿內可見黑色素顆粒;有的瘤細胞內可以看到假核仁包涵物和豐富的嗜曙紅胞漿。有的作者將瘤細胞分為5型,即大上皮細胞,小上皮細胞,梭形細胞,巨細胞和氣球細胞。其中大上皮細胞最為常見。
毗鄰腫瘤的食管黏膜區可見交界性改變,即該黏膜區有黑色素細胞增生並與腫瘤連結,而看到這一特徵是提示交界性改變的主要標誌。但生長速度很快的腫瘤可破壞或者遮蓋毗鄰黏膜上皮的交界性改變。
在鏡下,可見腫瘤往往向食管黏膜層及黏膜下層生長,表現為放射狀的著色斑;有的腫瘤向深部浸潤,可累及食管肌層,不過浸潤範圍超過食管壁的病例少見,有利於手術切除腫瘤。食管惡性黑色素瘤往往沿著食管黏膜上下垂直生長,容易侵犯局部的淋巴管、淋巴結和血管而發生局部淋巴轉移與全身血行轉移。DiConstanzo和Umacher(1987)以及其他作者曾對本病做過電鏡檢查,看到瘤細胞內有黑色素前體(premelanosome)和黑色素粒。
3.組織學特徵認為食管原發性黑色素瘤的組織學特徵包括以下3個方面:
(1)腫瘤細胞內含有經特殊染色而證實的黑色素顆粒(melaningranule)。
(2)腫瘤來源於食管鱗狀上皮交界痣(junetionalnevus)的惡變,交界痣細胞形成巢團狀,易發生惡性變而形成惡性黑色素瘤。
(3)鏡下見食管黏膜和黏膜下層間細胞呈放射狀生長,瘤細胞主要由3種細胞形成:①大上皮細胞:細胞呈多邊形,邊界清楚,黑色素細小而均勻;②小上皮細胞:細胞小,黑色素顆粒較少;③梭形細胞:所含黑色素顆粒不等。
4.好發部位食管黑色素瘤多位於食管中段和下段。Chalkiadakis等文獻,7%位於食管上段,7%位於食管中上段,24%位於食管中段,22%位於食管中下段,而40%的腫瘤發生於食管下段。由此可見80%以上的食管黑色素瘤好發於食管中下段。
5.轉移途徑食管原發性惡性黑色素瘤是一種迅速致死性疾病,原因是瘤細胞很容易通過淋巴道和血行兩種途徑發生轉移。
(1)淋巴道轉移:以局部和遠處淋巴結轉移多見,尤其是胸內淋巴結、腹腔淋巴結及鎖骨上淋巴結轉移更為常見;
(2)血行轉移:食管原發性惡性黑色素瘤經血行發生遠處轉移(播散)的主要部位依次為肝臟,肺,胸膜,腹膜,腦和骨。有的可轉移到左心房。根據Eng等在1989年的臨床統計資料,食管原發性惡性黑色素瘤病人在作出診斷時,30%~40%的病例已有淋巴結轉移或遠處播散,而且不論採用何種治療手段,85%的病例因腫瘤遠處轉移而死亡,病人的平均生存時間為13.4個月。
6.病理診斷標準在人體黑色素瘤的病理診斷方面,一度將腫瘤表面或毗鄰腫瘤的上皮組織的交界性改變視為診斷皮膚原發性惡性黑色素瘤的證據。1953年,Allen和Spitz擴大了交界性改變的概念,將其作為診斷黑色素瘤(包括內臟黑色素瘤)的首要標準。診斷原發性食管黑色素瘤的最為理想的標準如下。
(1)腫瘤應具備黑色素瘤的特徵性組織學表現,瘤細胞內應含有黑色素。
(2)腫瘤應該是起源於食管鱗狀上皮的交界性改變區。
(3)鄰近腫瘤的食管上皮組織內能找到含有黑色素的細胞,證實這種改變為交界性改變。
(4)經仔細的檢查,可以排除皮膚、眼球以及其他部位黏膜的原發性惡性黑色素瘤。
有的作者發現生長速度很快的食管原發性惡性黑色素瘤可以在短時間內形成潰瘍並侵及鄰近的上皮組織,因此有時確定交界性上皮組織的直接起源並非易事。此外,Eng等(1989)注意到食管轉移性惡性黑色素瘤的病例報導極為罕見,也使人難以理解。因為胃和小腸的黑色素瘤幾乎都是繼發於色素沉著。食管轉移性黑色素瘤病人均在發病後1年內死亡。
診斷檢查
 原發性食管惡性黑色素瘤檢查
原發性食管惡性黑色素瘤檢查實驗室檢查:
1.組織病理學檢查鏡檢黑色素瘤體大部分被食管鱗狀上皮覆蓋,其生長方式首先是黏膜下生長,而非侵入肌層,瘤細胞可呈巢狀、條索狀或腺泡樣排列,細胞呈多邊形或梭形,核大,常有粗大嗜酸性核仁,胞漿內可有黑色素顆粒。電鏡觀察胞質有數量不等結構,如前黑色素體,線粒體,內質網,游離核糖體,可見間橋。
2.免疫組化檢查分化程度差或無色素性惡性黑色素瘤普通染色難以與其他小細胞類腫瘤相鑑別,故需要做免疫組化檢查。S-100蛋白廣泛分布於惡性黑色素瘤組織內,用S-100蛋白抗體標記惡性黑色素瘤細胞的陽性率可高達90%,但其抗原專一性差,因此必須有HMB-45抗體的陽性表達才能確診。HMB-45的陽性率雖然只有50%~60%,然而它的交叉反應少,陽性細胞定位好,具有比較大的診斷價值與鑑別診斷價值。
其他輔助檢查:凡懷疑患有食管惡性腫瘤(包括黑色素瘤)的病人,除做常規的體格檢查之外,應進行以下各項檢查。
1.胸部X線平片檢查這兩項檢查對顯示肺實質內的轉移灶和胸內腫大淋巴結或轉移性淋巴結有臨床診斷意義。食管惡性黑色素瘤容易發生肺與胸膜的轉移,在臨床工作中要予以重視,以免造成漏診。
2.食管鋇餐造影檢查食管原發性黑色素瘤在做X線食管鋇餐造影檢查時,常表現為食管腔內型巨塊狀及息肉狀充盈缺損影,表面黏膜粗糙,往往有潰瘍龕影形成;腫瘤陰影的邊緣比較清晰和銳利。食管的轉移性黑色素瘤多累及局部食管壁的肌層,呈邊緣光滑的外壓性陰影。這些X線徵象亦無特異性,而且很難與食管鱗癌、癌肉瘤及平滑肌瘤相鑑別。此項檢查的主要意義在於能明確腫瘤的形態、大小、部位、食管受累的程度和範圍,有利於臨床醫生確定治療方案。
3.內鏡檢查食管黑色素瘤內鏡下表現為息肉樣或分葉狀腫物,基底較寬,腫物多位於食管中段或下段,為單發,有時可見衛星病灶;大多數腫瘤有潰瘍形成,質脆而且容易出血。如前所述,腫瘤表面在內鏡下可呈黑色、棕色、灰色或黑褐色,是不同程度的色素沉著所致。腫瘤因鉗取活檢而發大出血者極為罕見。Murray和Vasilakis認為食管黑色素瘤通過內鏡檢查鉗取活檢組織可以明確診斷。Joob等(1995)建議對所有導致食管腔梗阻的食管腔內的息肉樣腫瘤用特異性的單克隆抗原:HMB-45做免疫組化檢查。對HMB-45抗體呈陽性反應者,支持惡性黑色素瘤的診斷。內鏡活檢的診斷準確率為55%。據國內作者報導的食管原發性惡性黑色素瘤內鏡活檢的結果,誤診率很高,其原因有待探討。內鏡下細胞學塗片對診斷多無幫助。
4.腹部超聲檢查和上腹部CT掃描食管黑色素瘤通過淋巴道及血行可轉移或播散到腹腔淋巴結、肝臟和腹膜,而且肝臟的血行轉移瘤最為常見。通過腹部超聲與CT掃描,有可能發現腹腔內臟器的轉移瘤與轉移性淋巴結。
治療方案
原發性食管惡性黑色素瘤
原發性食管惡性黑色素瘤1.手術治療如果診斷明確,吞咽困難或吞咽疼痛症狀較重,病人的全身健康狀況較好,無腫瘤廣泛轉移或遠處轉移,就應該選擇外科手術治療。術式宜採用根治性全食管切除術或接近全食管切除術及食管-胃頸部吻合術,採用這種術式的主要原因是食管惡性黑色素瘤有沿著食管縱軸播散的傾向。術中應同時施行根治性淋巴結清掃術,而Joob等(1995)認為支持根治性淋巴結清掃術能夠改善病人的長期生存率,病人死亡的原因是腫瘤經血行廣泛轉移。Sabanathan和Eng(1990)也認為本病往往沿食管側壁廣泛蔓延,根治性食管切除術一方面可以緩解病人的症狀,另一方面也是惟一有希望得以治癒的治療手段。他們還提出病人在手術後不必進行輔助性的放射治療。據一些作者收集的臨床資料,食管惡性黑色素瘤的手術切除率在90%~96%以上,手術死亡率在5%以下。
2.放射治療主要適用於全身機能狀況差、手術風險高、有明確的轉移灶和拒絕手術治療的病人。有些食管惡性黑色素瘤病人經過單純放療後,可得到姑息性治療的效果,但單純放療的總體效果都不理想。快中子治療對皮膚黑色素瘤療效較好,對食管黑色素瘤的療效尚不清楚。Mills和Cooper(1983)報導,食管黑色素瘤病人接受根治性放療者,其平均生存時間僅為1.5個月。Turnbull等(1973)報導的1例病人在單純放療後卻生存50個月(4.1年),最後因腫瘤復發而死亡。劉復生等(1979)報告的1例食管原發性黑色素瘤病人在經過術前放療後施行了根治性食管切除術,術後隨訪3.3年時病人還存活。內外各大醫院和醫療單位治療食管鱗癌的經驗表明,食管鱗癌對放療呈中等敏感,術前放療有可能提高腫瘤的手術切除率而不能提高病人的長期生存率。Tumbull等報導的1例食管原發性惡性黑色素瘤病人經根治性放療後存活50個月,劉復生等報導的1例在術前放療後進行手術治療,病人術後生存3年以上。這2例病人雖屬個案報導,不具有代表性,然而這種臨床現象值得臨床醫生深思。
3.其他治療全身化療、生物治療以及激素治療等可以作為食管黑色素瘤的綜合輔助治療,然而這些療法的效果均不明顯。惡性黑色素瘤對化療藥不敏感,臨床上不作為常規治療。隨著分子生物學的發展,基因療法可能是治療食管惡性黑色素瘤的一種有前途的手段。
預後預防
 原發性食管惡性黑色素瘤治療藥
原發性食管惡性黑色素瘤治療藥飲食注意事項
首先,日常要少食脂肪脂肪是人體熱量的主要來源, 是每日必須的營養成份。但是對於黑色素瘤患者來說,飲食中不宜攝入過量的脂肪。其次,不宜攝入過量蛋白質黑色素瘤患者的飲食應該多樣化,有些黑色素瘤患者在放化療時常引起消化道反應導致消化功能減弱,或腫瘤增加機體消耗而引起營養不良,甚至惡液質,許多人就盲目地採用高蛋白膳食。殊不知高蛋白的膳食會增加胃腸道的負擔,使胃腸消化吸收功能更弱,並且對黑色素瘤的治療不利。
第三,宜多進食新鮮蔬菜和水果黑色素瘤晚期飲食需要注意的事項?新鮮蔬菜和水果中含有大量的維生素A、維生素C、給生素E等,具有較強的抗氧化作用,可清除體內自由基,阻斷致癌物亞硝胺的合成,抑制鱗狀上皮細胞的變性及癌細胞的發生,還具有增強機體免疫功能、促使潰瘍癒合等作用。黑色素瘤患者飲食應多食用綠葉蔬菜,要隨買隨吃,不要放置時間過長,最好不要過夜以避免放置導致的維生素等營養物質的損失。
